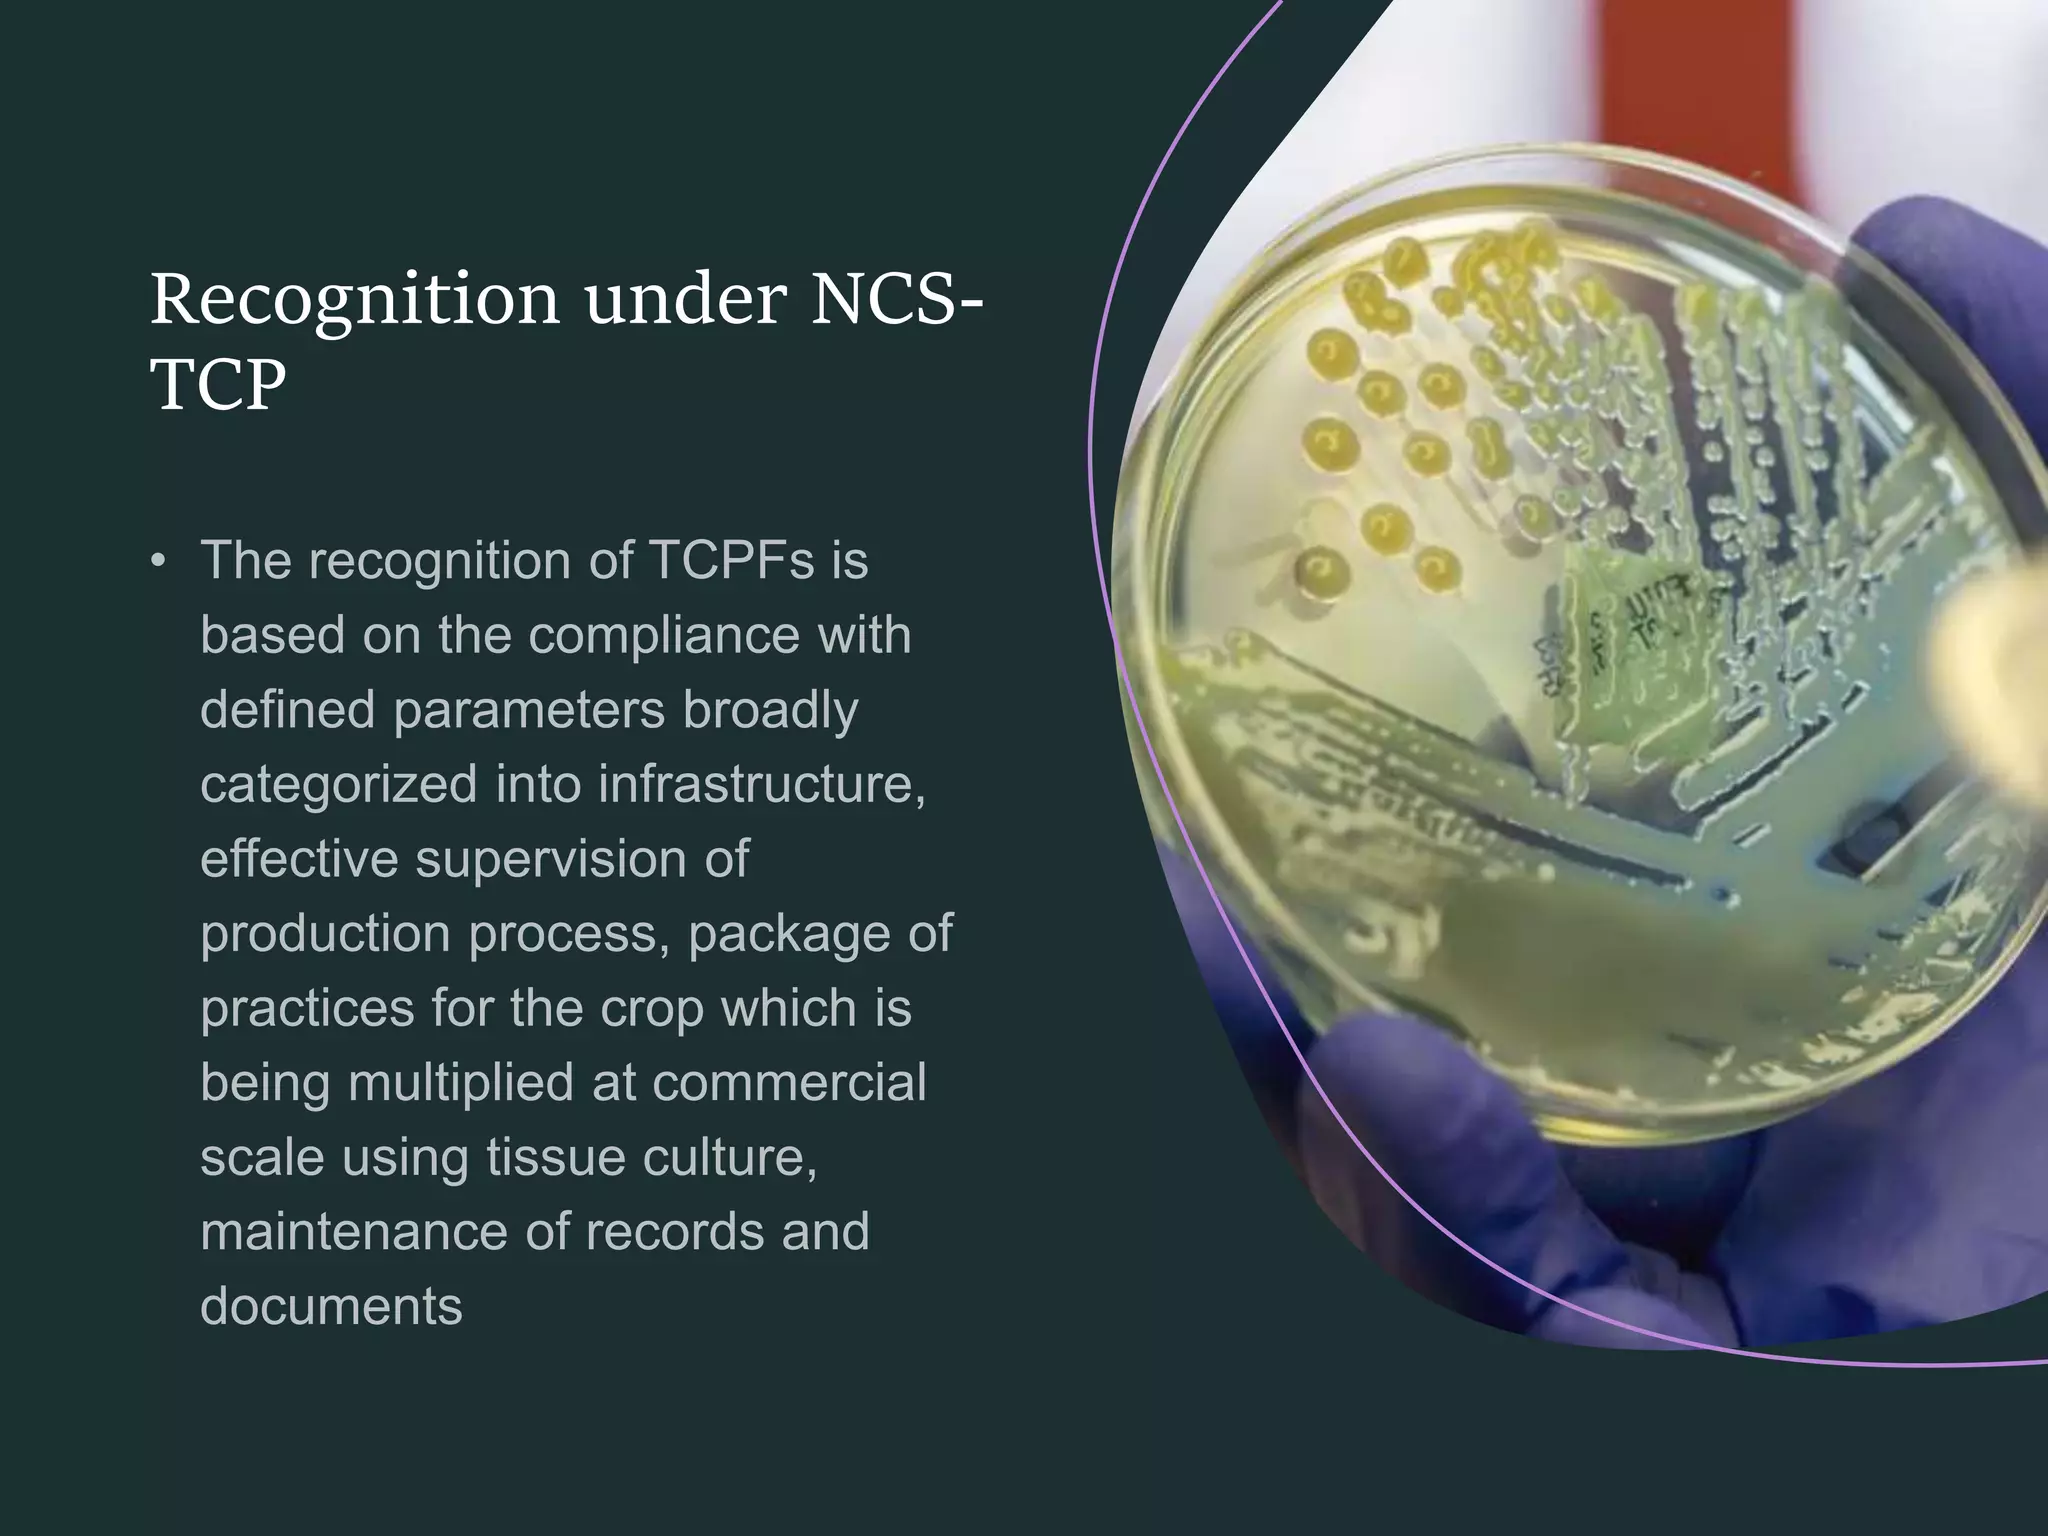

This lecture covers the major production constraints in banana cultivation, focusing on key physiological disorders, important pests and diseases, and integrated management practices. Emphasis is placed on the identification, symptoms, and control of disorders and pathogens affecting banana yield and quality. The content is essential for understanding sustainable banana production and effective disease management. Important academic keywords include physiological disorders, viral diseases, fungal diseases, bacterial diseases, and integrated management.
Introduction to Banana Production Constraints
- Banana is a major tropical fruit crop with significant economic importance.
- Production is limited by physiological disorders, pests, and diseases.
- Effective management is essential for sustainable yield and fruit quality.
Physiological Disorders in Banana
Kottavazhai
- Observed in cv. Poovan, mainly in Tamil Nadu.
- Fruits are conical, ill-filled, with a prominent central core and non-viable seeds.
- Spray 2,4-D at 20 ppm when last hand opens to prevent disorder.
Hard Lump
- Occurs in cv. Rasthali; pulp is pinkish-brown, firm, and tastes unripe.
- Spray 2,4-D at 1000 ppm or dip peduncle cut end for 5 minutes to reduce lumps.
Sunscald
- Caused by direct sun exposure on bunches and peduncle.
- Cover bunches and peduncle with banana or flag leaves to prevent damage.
Major Viral Diseases of Banana
Bunchy Top DiseasePathogen: Banana bunchy top virus (BBTV), transmitted by aphid Pentalonia nigronervosa.
Symptoms:
- Short, narrow leaves clustered at pseudostem apex (‘bunchy’ appearance).
- Leaf margins wavy and rolled upward in advanced stages.
Management:
- Remove affected plants with rhizome.
- Plant virus-free suckers.
- Control aphids with insecticides (e.g., 0.3% Rogor, 0.05% Monocrotophos).
Banana Bract Mosaic Virus
Pathogen: Banana bract mosaic virus, transmitted by Aphis gossypii and Pentalonia nigronervosa.
Symptoms:
- Discoloration and necrotic streaks on male bud bracts.
- Spindle-shaped discoloration on pseudostem.
Management:
- Early detection and removal of infected plants.
- Control vectors as for other viral diseases.
Banana Streak Virus
Pathogen: Banana streak virus, transmitted by citrus mealybug (Planococcus citri).
Symptoms:
- Foliar mosaic and necrotic streaks on leaves.
Major Fungal Diseases of Banana
Panama WiltPathogen: Fusarium oxysporum f.sp. cubense.
Symptoms:
- Yellowing and withering of leaves; petiole breaks and hangs.
- Longitudinal splitting of pseudostem; plant death.
Management:
- Remove infected plants; apply lime (2 kg/pit) and fallow for 6 months.
- Grow resistant varieties (Dwarf Cavendish, Poovan, Nendran).
- Crop rotation with paddy in wetland areas.
- Apply carbendazim (50–60 mg) in corm at 45° angle.
Sigatoka Leaf Spot
Pathogen: Mycosphaerella musicola.
Symptoms:
- Yellowish-green streaks along veins, enlarging into elongated spots.
- Coalescence of spots leads to leaf drying.
Management:
- Spray copper oxychloride or carbendazim (500 g/ha).
- Avoid close planting to reduce humidity.
Major Bacterial Diseases of Banana
Moko WiltPathogen: Ralstonia solanacearum (formerly Pseudomonas solanacearum).
Symptoms:
- Yellowing starts from inner leaves, spreads upward; wilting of all leaves.
Management:
- Ensure good drainage.
- Biological control with Pseudomonas fluorescens.
- Crop rotation with non-hosts (e.g., sorghum).
Tip Over (Heart Rot)
Pathogen: Erwinia carotovora.
Symptoms:
- Rotting of central tender leaf; pseudostem detaches easily from corm.
- Bacterial ooze from corm and pseudostem edges.
Management:
- Use disease-free suckers.
- Grow resistant varieties (e.g., Poovan).
Integrated Management Practices and Harvest
- Adopt integrated pest and disease management (IPDM) for sustainable production.
- Use resistant varieties and healthy planting material.
- Practice crop rotation and proper field sanitation.
- Apply recommended fungicides and insecticides judiciously.
- Bunches mature 100–150 days after flowering.
- Average yields (t/ha/year): Poovan 40–50, Monthan 30–40, Robusta 50–60, Dwarf Cavendish 50–60.
Objective Questions
Q1. Which banana cultivar is specifically affected by the physiological disorder "Kottavazhai"?
A. Poovan
B. Rasthali
C. Nendran
D. Monthan
Answer: A
Q2. What chemical and concentration is recommended to overcome Kottavazhai disorder in bananas?
A. 2,4 D 20 ppm
B. 2,4 D 1000 ppm
C. Carbendazim 50 mg
D. Monocrotophos 0.05%
Answer: A
Q3. Which physiological disorder in banana is characterized by pinkish brown, firm pulp and occurs in cv. Rasthali?
A. Kottavazhai
B. Hard lump
C. Sunscald
D. Main stalk rot
Answer: B
Q4. What is the main vector for Banana Bunchy Top Virus?
A. Planococcus citri
B. Aphis gossypii
C. Pentalonia nigronervosa
D. Erwinia carotovora
Answer: C
Q5. Which management practice is NOT recommended for Panama wilt in banana?
A. Application of lime @ 2kg/pit
B. Growing Dwarf Cavendish
C. Spraying copper oxy chloride
D. Crop rotation with paddy
Answer: C
Q6. Which fungal disease of banana is caused by Mycosphaerella musicola?
A. Panama wilt
B. Sigatoka leaf spot
C. Moko wilt
D. Banana streak
Answer: B
Q7. Which banana cultivar has the highest reported yield per hectare per year?
A. Poovan
B. Monthan
C. Robusta
D. Rasthali
Answer: C
Q8. Which bacterial disease is mostly seen in tissue cultured banana plants?
A. Moko wilt
B. Tip over or heart rot
C. Panama wilt
D. Banana streak
Answer: B
Q9. What is the recommended chemical for controlling banana aphid vectors?
A. Carbendazim
B. Rogar
C. Copper oxy chloride
D. Lime
Answer: B
Q10. Which pest transmits Banana Streak Virus?
A. Pentalonia nigronervosa
B. Aphis gossypii
C. Planococcus citri
D. Erwinia carotovora
Answer: C
This lecture covers the essential aspects of banana (Musa spp.) cultivation, including suitable soil and climate requirements, planting methods, high density planting techniques, and effective nutrient and water management. Emphasis is placed on propagation, field preparation, intercultural operations, and maximizing productivity for commercial banana production.
Introduction to Banana
- Banana (Musa spp.) is a major fruit crop and staple food in tropical regions.
- Origin: South East Asia; called ‘Apple of Paradise’.
- Main producing states: Tamil Nadu, Kerala, Maharashtra, Andhra Pradesh, Bihar.
- Edible bananas are mostly hybrids of M. acuminata and M. balbisiana.
- Fruits develop by parthenocarpy (without fertilization).
Soil and Climate Requirements
Soil:
- Deep, well-drained soils rich in organic matter are ideal.
- Optimum soil pH: 5.5–8.0.
- Soil depth: At least 1 meter.
Climate:
- Prefers humid tropical climate.
- Temperature range: 10°C to 40°C (optimum ~23°C).
- Altitude: Up to 1500 m above mean sea level.
- Rainfall: Minimum 100 mm/month is beneficial.
- High wind velocity (>80 m/hr) can damage plants.
Planting Season and Propagation
Planting Season:
- Wet land: Feb–Apr (Poovan, Rasthali, Monthan), Apr–May (Nendran, Robusta).
- Garden land: Jan–Feb, Nov–Dec.
- Padugai land: Jan–Feb, Aug–Sep.
- Hill banana: Apr–May (lower Palani hills), Jun–Aug (Sirumalai).
Propagation Methods:
- By suckers: Sword suckers (vigorous, early bearing) and water suckers (less vigorous).
- Average sucker weight: 1.5–2 kg.
- Micropropagation (tissue culture) for rapid multiplication.
Sucker Pretreatment and Field Preparation
Pretreatment of Suckers:
- Trim roots and decayed corm portions; cut pseudostem to 20 cm above corm.
- For wilt-prone varieties, dip corm in 0.1% carbendazim for 5 min.
- Pralinage: Dip corm in clay slurry and sprinkle with 40 g carbofuran 3G per sucker to control nematodes.
- Alternative: Dip in 0.75% monocrotophos, shade dry 24 hours before planting.
Field Preparation:
- Deep ploughing and leveling of land.
- Dig pits (45 cm x 45 cm x 45 cm); refill with topsoil, 10 kg FYM, 250 g neem cake, 50 g lindane 1.3%.
Spacing and High Density Planting
- Garden land: 1.8 x 1.8 m (3086 plants/ha) or 1.5 x 1.5 m (4444 plants/ha).
- Wet land: 2.1 x 2.1 m (2267 plants/ha).
- Hill: 3.6 x 3.6 m (750 plants/ha).
- High density: 3 suckers/pit at 1.8 x 3.6 m (4600 plants/ha).
Irrigation and Water Management
- Immediate irrigation after planting; life irrigation on 4th day.
- Subsequent irrigation: Weekly (garden land), every 10–15 days (wetland).
- Drip irrigation: 15 L/plant/day (planting–4th month), 20 L/plant/day (5th month–shooting), 25 L/plant/day (shooting–15 days before harvest).
Nutrient Management
- Apply N, P, K as per land type and variety (see table below).
- Use neem-coated urea for N application.
- Apply N & K in 3 splits (3rd, 5th, 7th month); P at 3rd month.
- For tissue culture plants, apply 50% extra fertilizer at 2nd, 4th, 6th, 8th month.
- Biofertilizers: Azospirillum and Phosphobacteria (20 g each at planting and 5th month).
| Land/Variety |
N (g/plant/yr) |
P (g/plant/yr) |
K (g/plant/yr) |
| Garden land (other than Nendran) |
110 |
35 |
330 |
| Garden land (Nendran) |
150 |
90 |
300 |
| Wet land (Nendran) |
210 |
35 |
450 |
| Wet land (Rasthali) |
210 |
50 |
390 |
| Wet land (Poovan, Robusta) |
160 |
50 |
390 |
Fertigation and Micronutrient Management
Fertigation:
- Apply 25 L water/plant/day with 200:30:300 g N:P2O5:K2O/plant using water-soluble fertilizers.
- For cost-saving, use 30% recommended N & K via fertigation; full P as basal at 2nd month.
Micronutrients:
- Spray ZnSO4 (0.5%), FeSO4 (0.2%), CuSO4 (0.2%), H3BO3 (0.1%) at 3, 5, 7 months after planting.
Intercultural Operations and Special Practices
- Bi-monthly digging and earthing-up.
- Desuckering: Remove side suckers monthly.
- Remove and burn dry/dead leaves.
- Remove male flower a week after last hand opens.
- Propping: Support bunches with bamboo or casuarina poles to prevent wind damage.
Growth Regulators and Bunch Management
- Spray 2,4-D at 25 ppm after last hand opens to improve bunch grade and reduce seediness (Poovan).
- Spray CCC (1000 ppm) at 4th and 6th month to enhance yield.
- Spray plantozyme (2 ml/L) at 6th and 8th month for higher yield.
- Cover bunches with transparent polyethylene sleeves (2–4% ventilation) after last hand opens.
Intercropping and Cropping System
- Suitable intercrops: Leguminous vegetables, beetroot, elephant foot yam, sunhemp.
- Incorporate sunhemp at 45 days to reduce nematode build-up.
- Avoid cucurbitaceous vegetables as intercrops.
Objective Questions
Q1. Which two species are the main contributors to edible banana hybrids?
A. M. acuminata and M. balbisiana
B. M. paradisiaca and M. sapientum
C. M. acuminata and M. sapientum
D. M. balbisiana and M. paradisiaca
Answer: A
Q2. What is the optimal soil pH range for banana cultivation?
A. 4.0 – 5.0
B. 5.5 – 8.0
C. 7.5 – 9.0
D. 6.5 – 9.5
Answer: B
Q3. Which type of sucker is preferred for banana propagation due to its vigor and early bearing?
A. Water sucker
B. Sword sucker
C. Leaf sucker
D. Root sucker
Answer: B
Q4. What is the recommended pit size for planting banana?
A. 30 cm3
B. 45 cm3
C. 60 cm3
D. 90 cm3
Answer: B
Q5. For high density planting, what is the recommended spacing and number of plants per hectare?
A. 1.5 x 1.5 m, 4444 plants
B. 2.1 x 2.1 m, 2267 plants
C. 1.8 x 3.6 m, 4600 plants
D. 3.6 x 3.6 m, 750 plants
Answer: C
Q6. Which chemical is used for pralinage to control nematodes in banana suckers?
A. Carbendazim
B. Lindane
C. Carbofuran
D. Monocrotophos
Answer: C
Q7. What is the recommended fertilizer application schedule for N and K in banana cultivation?
A. Single application at planting
B. In 3 splits at 3rd, 5th, and 7th month
C. In 2 splits at 4th and 8th month
D. Monthly application throughout the year
Answer: B
Q8. Which micronutrient combination is sprayed at 3, 5, and 7 months after planting to improve banana yield and quality?
A. ZnSO4, FeSO4, CuSO4, H3BO3
B. ZnSO4, MgSO4, CuSO4, H2SO4
C. FeSO4, MnSO4, CuSO4, H3BO3
D. ZnSO4, FeSO4, CaSO4, H3BO3
Answer: A
Q9. Which growth regulator is sprayed at 4th and 6th month after planting to enhance banana yield?
A. 2,4-D
B. Plantozyme
C. CCC
D. GA3
Answer: C
Q10. Which crop should be avoided as an intercrop in banana plantations?
A. Sunhemp
B. Beet root
C. Elephant foot yam
D. Cucurbitaceous vegetables
Answer: D